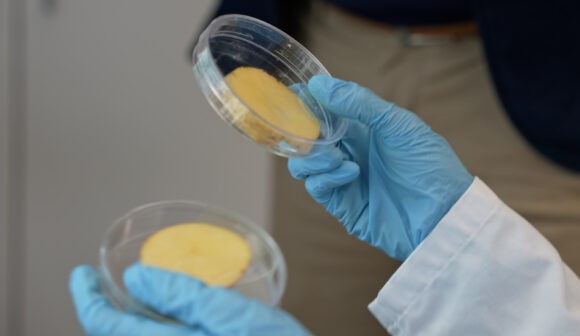

Pitching an invention to expert and investor panels is a critical part of the journey to becoming an entrepreneur. Pitch training is the key to success.
“Have a great pitch!”
It’s Friday morning at The Kitchen at Aarhus University, and one of the startup advisors has just introduced the lineup of seven researchers from Spin-outs Denmark. In just a few minutes, they’ll take the stage to pitch their inventions to a panel of industry experts and a small audience.
These pitches mark the conclusion of Pitch Week – a one-week crash course designed to train researchers in the art of pitching. It’s a key element of the Spin-outs Denmark program.
Just before the first pitch, the startup advisor reminds them of one important point:
“You must explain it to me so I can explain it to my mom this weekend. That’s the bar we’re setting.”
Transforming complex knowledge
Pitching is a crucial step for any researcher aiming to become an entrepreneur, and during Pitch Week, the researchers get a real opportunity to refine their presentation skills.
Starting with online pitching the week before, the researchers wrap up their preparation by meeting in The Kitchen for a dress rehearsal in front of startup advisors and each other on Thursday before the final pitch.
‘Learning to pitch is an essential part of the entrepreneurial training for our postdocs. These researchers come from a world where it’s important to know all the facts and clearly explain how the invention works and the science behind it. But that’s not what matters in a good pitch. Here, the key is to transform complex knowledge into clear, compelling stories that open doors to funding and collaboration,’ says Susan Henriksen, Program Manager at Spin-outs Denmark.
One of the pitchers this Friday morning is Andreas Gejl Madsen. He is a postdoctoral researcher at the University of Southern Denmark and co-founder of HoloTile Photonics.
‘It’s been really good. A great mix of online and in-person sessions which works well, because at home you can focus and work in peace, and then collaborate when you’re here at The Kitchen,’ says Andreas.
In Thursdays feedback session, he gets a lot of praise from the small group of researchers and advisors.
‘You have good rhetorical skills. I like how you use ‘What does that mean?’ as a transition,’ says one startup advisor.
Another advisor points out how important it is to use the right words:
‘You say, ‘We believe the market is ready.’ Don’t say that – the market is ready!’
‘The most valuable part is probably that the feedback comes from people who aren’t involved in the technology. You can become blind to your own work. Something I see as obvious isn’t obvious to those outside my field, and you can’t always understand what others don’t understand. It has to make sense to everyone,’ says Andreas.
Fixed the problem or made it worse?
This is a common challenge for researchers transitioning from academic presentations to pitching their inventions to investors. While researchers are accustomed to diving deep into details, investors are looking for clarity and impact.
’I had pitched a lot leading up to Pitch Week – almost every day – so I arrived with a solid starting point. That allowed me to really test how many people actually understood the idea,’ says Emil Zanchetta Ulsig, a postdoctoral researcher from Aarhus University who is also pitching this week.
He is part of Spin-outs Denmark with QVersion that develops tunable mid-infrared lasers for precision gas sensing.
‘Already at that stage, there were key points that didn’t land, which made it clear I needed to go back and look at the structure. How could I improve the visuals or explain the solution more clearly? That kind of insight came right from day one. Then you come back the next day thinking you’ve fixed the problem, only to realize you’ve made it worse,’ Emil laughs.
That’s a challenge Andreas can relate to.
‘I have to walk a fine line with my illustration. The goal is to provide just enough context for people to latch onto, but if I give too much, they end up thinking I’m trying to build a CT scanner,’ he says about his first pre-commercial prototype of HoloVAM – a holographic bioprinter that fabricates entire 3D tissue structures in seconds.
Collaborative spirit
On Friday, Andreas is second in line at the final pitch. He commands the stage with confidence and ends his pitch within the required ten-minute limit.
Afterwards, the two industry experts are impressed with the pitch but offer some constructive criticism.
‘You do a good job, but it could be even more simple. Make it less complicated,’ one of them says.
Emil also receives great feedback on his pitch, and overall, the two industry experts are impressed with all seven pitchers.
‘You were all able to describe your inventions and ideas, and that’s not always the case,’ is the last remark to the lineup.
That was also the overall impression Susan Henriksen took away from the pitches.
‘This time, pitch elements were even more deeply integrated into the Masterclasses, and it really showed during the final pitch. Our researchers are already focused on what their inventions can do for customers, and, as a result, the potential societal impact. We’ve been very impressed with this cohort, which is larger than the previous ones. Their collaborative spirit and willingness to support one another have been a real pleasure to witness,’ says Susan Henriksen.
For both Andreas and Emil, pitch week has been a great experience.
‘There’s always something you can improve, and that’s the great thing about a space like this. We came in with something we’ve pitched many times, but here, we could test it and experiment a bit. You get to try things out,’ says Emil.
’If I were to prepare a new pitch, I’d focus on simplifying and showing more clearly what the product looks like from the end user’s perspective. At the beginning of the week, my pitch was much more focused on the research problem and what it solves. But that doesn’t really matter to the people who are considering investing in us,’ concludes Andreas.
The seven researchers pitching at this Pitch Week were:
HoloTile Photonics
QVersion
Selene
ERLEtek
Collaborome
GHG Tracker
Sustainable Entrepreneurial Ecosystem
The remaining researchers from Cohort 5 will pitch at the end of August.
Spin-outs in this story

HoloTile Photonics
Bioprinting platform using light to fabricate 3D tissue in under 30 seconds.

QVersion
Integrated tunable lasers for compact and effective sensing and communication in the mid-infrared.

ERLEtek
A technology company that develops mobile concrete 3D printers for the construction industry.
Collaborome
Develops the next generation of biopesticides using consortia of bacteria, called collaboromes.

Selene
A Cyber Threat Intelligence system able to mine and analyze data from heterogeneous sources (e.g. darkweb).
Spin-outs Denmark is a unique program that invests in researchers who create more impact by starting research-based companies.







